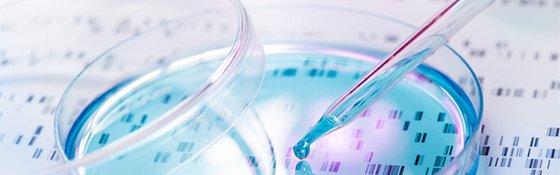

ಟ್ವೀಟ್ಗಳು
- ಟ್ವೀಟ್ಗಳು
- ಟ್ವೀಟ್ಗಳು & ಪ್ರತಿಕ್ರಿಯೆಗಳು
- ಮಾಧ್ಯಮ
@EPOorg ತಡೆಹಿಡಿಯಲಾಗಿದೆ
ನೀವು ಖಚಿತವಾಗಿಯೂ ಈ ಟ್ವೀಟ್ಗಳನ್ನು ನೋಡಲು ಬಯಸುವಿರಾ? ಟ್ವೀಟ್ಗಳನ್ನು ನೋಡುವುದು @EPOorg ಅವರನ್ನು ತಡೆತೆರವುಗೊಳಿಸುವುದಿಲ್ಲ.
-
I've attended
#SearchMatters and it is a must for professional searchers!https://twitter.com/epoorg/status/824946568344268800 … -
This programme gives you the chance to work on actual case files & run prior-art searches: http://buzz.mw/b1z0z_f pic.twitter.com/lFX7059NvG

-
Find out about upcoming law changes in China & Hong Kong, sign up here: http://buzz.mw/b1z02_f pic.twitter.com/rBvEnzVZGk

-
Have you attended
#SearchMatters yet? Those who have say it's a must for any search professional! http://buzz.mw/b1z0o_f -
All editions of the European Patent Convention & other legal texts are now available online: http://buzz.mw/b1z0r_f pic.twitter.com/UULKSMbBbe

-
What improvements were made to the European Patent Register in 2016? http://buzz.mw/b1z07_f pic.twitter.com/qWfal8YiKL

-
#biotech accounts for about 4% of patent applications filed at the EPO. Find out more here: http://buzz.mw/b1z09_f pic.twitter.com/NMikPEkvbm
-
Share this with your university if you think students should be aware of the European patent system: http://buzz.mw/b1z0u_f
-
How do patent families work in
#Espacenet? Find out from an EPO expert in this free webinar! http://buzz.mw/b1z0m_f pic.twitter.com/njAit0YrpW
-
Thinking about sitting the EQE? Then this is for you! http://buzz.mw/b1z03_f pic.twitter.com/2eFFhi3pHK

-
Go to page 9 to find out about the changes to the IPC as from 1 January 2017: http://buzz.mw/b1z0y_f
-
EPO experts share their knowledge and expertise in these free webinars: http://buzz.mw/b1z01_f Sign up now if interested!
-
This programme offers you the chance to work as an intern on search, examination & opposition. Apply now! http://buzz.mw/b1z0a_f
-
There's no such thing as the perfect patent search, but this course can help you search more effectively: http://buzz.mw/b1z06_f
-
It's your last chance to join one of our exclusive workshops at 14pm and dive into
#PatentAssessment w/@jstan@EPOorg#Unconv17 -
Here (on page 5) are our answers to two of the most frequently asked questions about
#Espacenet: http://buzz.mw/b1z0q_f -
#IPR intensive industries 42% of EU GDP succeed to articulate their value using different#IP tools sinergically#valuearticulation@EPOorgpic.twitter.com/qRXlW5zWlc
-
The biotechnology sector is very important to the European economy. Read about
#biotech patents @ the EPO here: http://buzz.mw/b1z0g_l pic.twitter.com/SdBPxkjMFM
-
We’re happy to be present at
#unconv17 with a workshop on Patent Assessment. Looking forward to meeting you there http://unconvention.eu/ https://twitter.com/EYIF/status/818777675200393217 …
ಲೋಡಿಂಗ್ ಸಮಯ ಸ್ವಲ್ಪ ತೆಗೆದುಕೊಳ್ಳುತ್ತಿರುವಂತೆನಿಸುತ್ತದೆ.
Twitter ಸಾಮರ್ಥ್ಯ ಮೀರಿರಬಹುದು ಅಥವಾ ಕ್ಷಣಿಕವಾದ ತೊಂದರೆಯನ್ನು ಅನುಭವಿಸುತ್ತಿರಬಹುದು. ಮತ್ತೆ ಪ್ರಯತ್ನಿಸಿ ಅಥವಾ ಹೆಚ್ಚಿನ ಮಾಹಿತಿಗೆ Twitter ಸ್ಥಿತಿಗೆ ಭೇಟಿ ನೀಡಿ.


 Maria Lampert
Maria Lampert
 EuropeanPatentOffice
EuropeanPatentOffice
 EYIF
EYIF
 MITO Technology
MITO Technology

 Marco Gorini
Marco Gorini